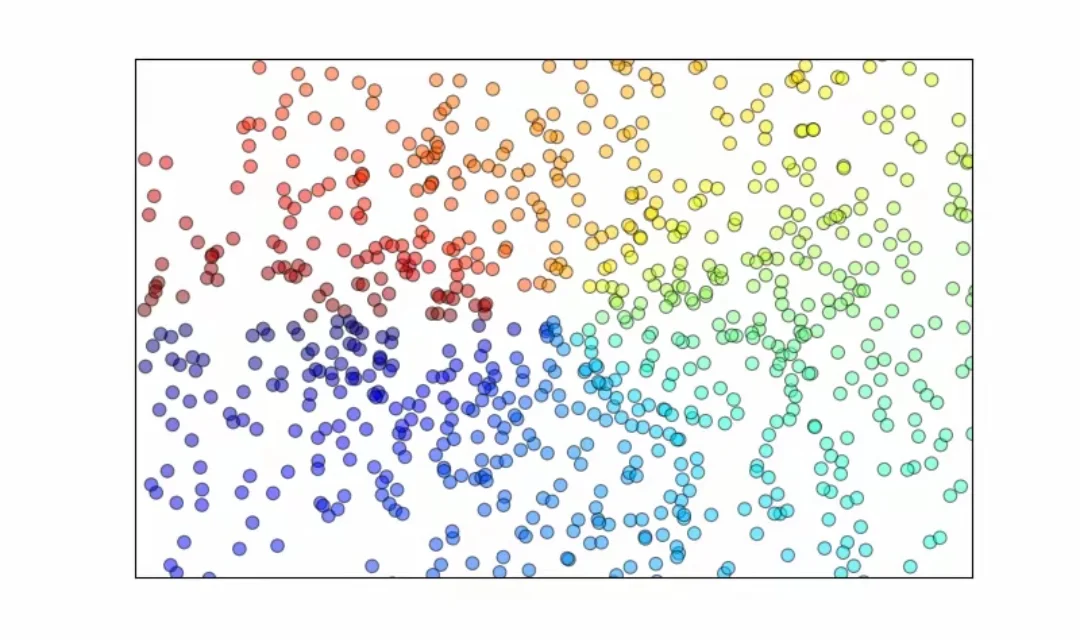
目标识别 迁移学习 自适应

目标识别 迁移学习 自适应

Python深度学习,代码改进、代码跑通
帮写修改程序调试代码复现软件。机器学习、深度学习调试修改、擅长等代码调试与优化,解决各类深度学习难题。项目支持可协助运行及跑通上的项目,提供数据集等 代码改进,跑通,预测模型 模型优化,增加模块,文章复现,预测,微调,融合,深度学习,机器学习程。环境调试,代码调通,模型优化,模型修改,时间序列,机器学习数据处理等开发工程,项目主攻,训练模型,优化,增加模块训练跑通 算法性能提升,算法优化,微创新,残差网络,提升算法小创新点,预测模型,对比预测,模型修改,优化网络cnn训练,融合创新,机器学习,数学建模,人工智能,数据处理,调参,优化,环境配置,代码解读,代码分析。训练集和测试集对结构好的 进行训练,数据预处理,数据增强,学习率调度器,进阶提升CNN性能,LSTM模 A!可提供代码讲解,代码修改,提供源码和改进方案。提供深度学习代码及实现图神经网络(改进+优化+创新): 图卷积神经网络 网络模型代码讲解等等.深度学习、计算机视觉、CV、多模态3D检测,人脸识别Python深度学习AI算法模型训练定制服务。
#深度学习 #机器学习 #深度学习与神经网络 #提供思路和创新点 #空间自相关 #计算机视觉 #系统稳定性
帮写修改程序调试代码复现软件。机器学习、深度学习调试修改、擅长等代码调试与优化,解决各类深度学习难题。项目支持可协助运行及跑通上的项目,提供数据集等 代码改进,跑通,预测模型 模型优化,增加模块,文章复现,预测,微调,融合,深度学习,机器学习程。环境调试,代码调通,模型优化,模型修改,时间序列,机器学习数据处理等开发工程,项目主攻,训练模型,优化,增加模块训练跑通 算法性能提升,算法优化,微创新,残差网络,提升算法小创新点,预测模型,对比预测,模型修改,优化网络cnn训练,融合创新,机器学习,数学建模,人工智能,数据处理,调参,优化,环境配置,代码解读,代码分析。训练集和测试集对结构好的 进行训练,数据预处理,数据增强,学习率调度器,进阶提升CNN性能,LSTM模 A!可提供代码讲解,代码修改,提供源码和改进方案。提供深度学习代码及实现图神经网络(改进+优化+创新): 图卷积神经网络 网络模型代码讲解等等.深度学习、计算机视觉、CV、多模态3D检测,人脸识别Python深度学习AI算法模型训练定制服务。
#深度学习 #机器学习 #深度学习与神经网络 #提供思路和创新点 #空间自相关 #计算机视觉 #系统稳定性
夜雨聆风
